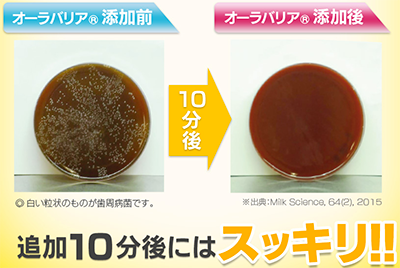
特許成分『オーラバリア』配合【オーラルデント】

他人の口臭の方がきになる?

とある調査で自分の口臭が気になる人は55.9%だったのに対し、なんと他人の口臭の方が気になると答えた人が84.7%もいるのです。
自分の口臭には気が付かないけれど、周りはあなたの口臭を不快と思っているかもしれません。
他人の口臭は指摘しない

50歳以上の女性59名に友人に口臭を指摘するかと調査したところ、すると答えた人はわずか6.8%。
ほとんどの人が自分の口臭に不快感を持っていても指摘はしてくれません。
なかなか言えることではありませんね。
特許成分『オーラバリア』配合【オーラルデント】の公式サイトはこちら♪
口の臭いの原因は?
においの原因は口内細菌
これは口の中の細菌が原因。
食べ物の粕や下の汚れなどのタンパク質をにおい物質である硫化水素やメチルメチカプタンへ変えてしまうから。
口内細菌は口臭だけでなく口内トラブルを引き起こす原因にもなります。
唾液が減るとにおいが増える?

唾液は抗菌力を持っており、健康な口内環境を保ってくれる働きがあります。
しかし年齢を追うごとに唾液量は減少してしまいます。
唾液の量が減ってしまうと、口内細菌は増加の一途。
口臭を予防するためには原因菌と唾液力にアプローチすることが重要です。
特許成分『オーラバリア』配合【オーラルデント】の公式サイトはこちら♪
オーラルデントの5つの特徴は?
① 2つのブロックで口内ケア
またにおいが生じる仕組みに対してもブロック。
オーラバリアの2つのブロックが2つの力で原因菌をブロックします。
② 特許成分オーラバリアでが口臭ケア

特許成分オーラバリアは、母乳に含まれるラクトフェリン、ラクトパーオキシダーゼという2つの天然由来成分。
ラクトフェリンは唾液や母乳に含まれる成分。口内環境を整えてくれます。
ラクトパーオキシダーゼは哺乳類の唾液や乳に含まれる酵素で、唾液の分泌をサポートしてくれます。
③ においのもとにアプローチ

よくある口臭対策のミント錠剤などは香りで口臭をごまかしているだけですが、特許成分配合のオーラバリア配合オーラルデントは口臭をほかの香りなどでごまかさず、においの素にアプローチし口臭をケアします。
④ 口内環境を整える4つの成分配合

ユーカリエキス、ビフィズス菌、プロポリス、コエンザイムQ10の4つの成分が、口内環境をしっかりとサポートしてくれます。
⑤ においの原因となる歯周病にもアプローチ
口臭は歯周病ともかかわりが深く、オーラルデントは高い殺菌力で歯周病予防もできることが実証。
10分で歯周病菌をすっきり除去する働きが!
特許成分『オーラバリア』配合【オーラルデント】の公式サイトはこちら♪
オーラルデントの口コミは?
家族から口臭がひどいといわれ・・・
自分の口臭はなかなか気が付かないもの。
自分では口臭はないと思っていましたが、ある時家族から、実は口臭がひどいといわれ、ショックを受けました。口臭を治す方法を探していたところオーラルデントに出会い、さっそく使うことに。
驚いたのはその即効性。1回使ってみただけで、口臭が消えたと家族も驚き。
口臭はデリケートなもの。人にはなかなか言えないし聞けません。
息が臭いのは歯周病の原因にもなりかねません。
口のにおいが気になる人にぜひともおすすめしたいです!
ひどかった寝起きの口臭が劇的に改善
普段はエチケットで口臭には気を払い、サプリメントや口臭ケア用品を頻繁に使っていたので気になりませんでしたが、どうしても寝起きの口臭、特に歯が臭いのが気になり、口コミで人気のオーラルデントえお使い始めました。
使い始めてさほど時間がたたないうちに効果を実感できました。
朝のあの嫌な口臭を感じなくなったのです!
寝起きの口臭がないのはとてもすっきりして気持ちがいいもの。
今ではほかの口臭ケアアイテムも必要なくなりました。
特許成分『オーラバリア』配合【オーラルデント】の公式サイトはこちら♪
口臭の不快感に悩むあなたへ京都やまちやの【オーラルデント】
お口の環境を整える充実したサポート成分を配合。
唾液の分泌を促し、唾液がもつ抗菌活用性を高め、原因菌をブロック!
さらに、臭い物質への変換をストップします!
口臭と関係の深い歯周病菌にも高い殺菌能力を発揮することが
実証されています。口臭だけでなくお口のトラブルにもおすすめ!
タブレットなので外出先にも持ち運びが便利!
どれを試してもダメだったあなた様・・・
お試しいただければ、すぐにご満足いただけると思います!
自信があるから定期便をおすすめします!
https://www.yamachiya.co.jp/landing_page/oraldent_L01_1.php
◆ある調査を知ってますか?
◆口の臭いの原因は?
◆オーラルデントの5つの特徴は?
◆オーラルデントの口コミは?
口の臭い
口臭
エチケット
歯周病
お口トラブル
オーラバリア
オーラルデント
口臭 改善
息 臭い
虫歯 口臭
口臭 病気
寝起き 口臭
歯石 口臭
コーヒー 口臭
口臭 サプリ
口臭ケア
口臭い女
歯が臭い
口臭 治す
歯垢 臭い
朝 口臭
口臭い 芸能人
口が臭い 原因
歯周病 うつる
自分の口臭
口臭 治し方









































